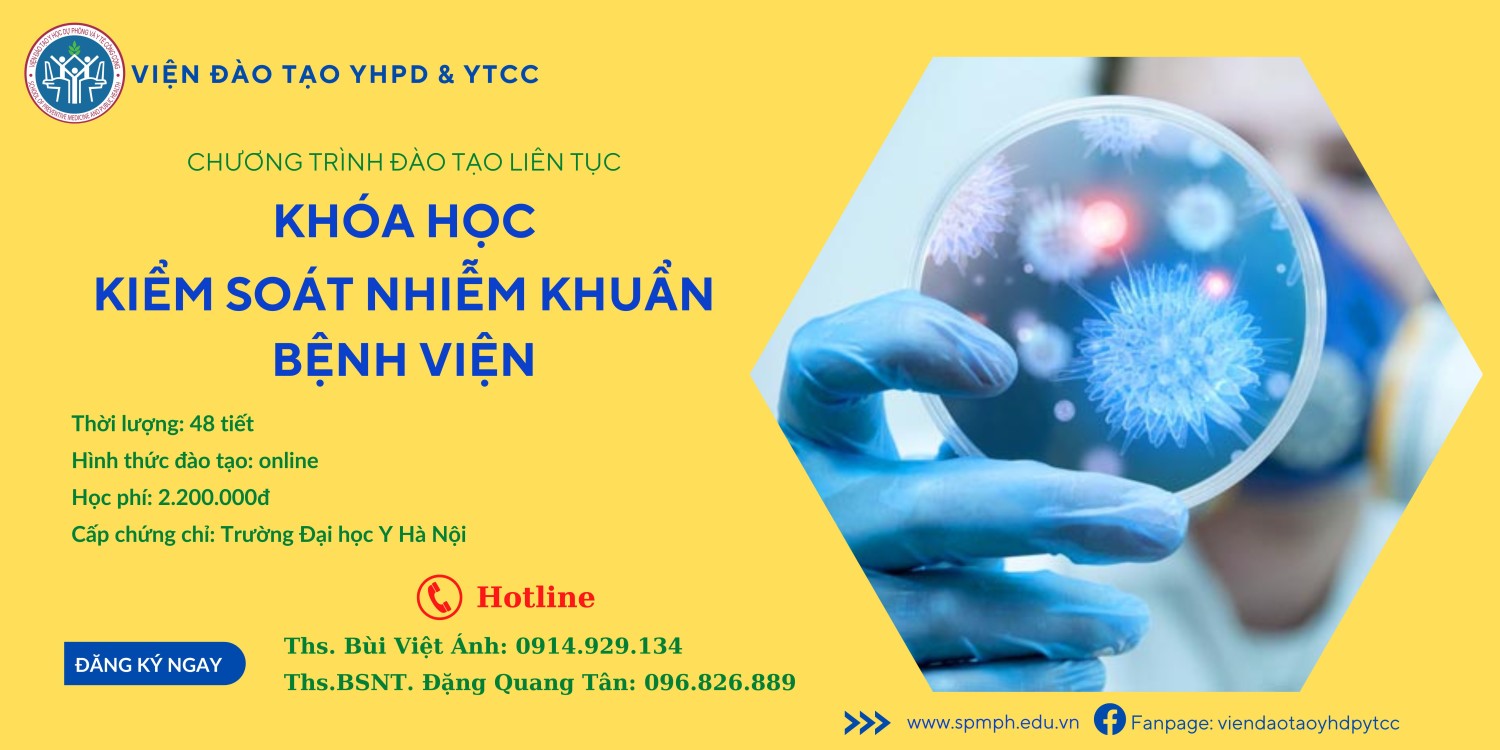

Ngày 17/10/2022, tại hội trường lớn nhà A1, buổi Lễ khai giảng - Năm học 2022-2023 đã được diễn ra trong không khí hân hoan, phấn khởi hướng tới kỷ niệm 120 năm thành lập Trường Đại học Y Hà Nội(1902-2022).Trong buổi lễ, Nhà trường đã trao tặng các danh hiệu cho các đơn vị hoàn thành suất sắc các nhiệm vụ được giao, trong đó có tập thể Viện Đào tạo YHDP & YTCC.
Đọc thêm

.jpg)


